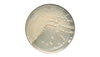
BD BBL Sabouraud Dextrose Agar (Deep Fill) Plate – Nonselective Fungal Medium, 100 Plates, 147-Day Shelf Life
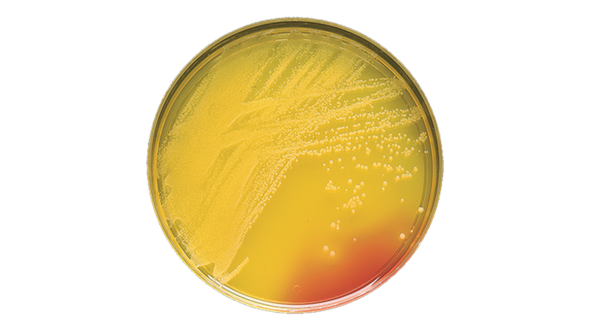
BD BBL Mannitol Salt Agar Plate – Selective Isolation Medium, 100 Plates per Pack, 98-Day Shelf Life

Description
BD BBL Sabouraud Dextrose Agar (deep Fill) Plate is designed for laboratories and clinicians who need reliable fungal culture results. When accuracy and consistency matter, this deep-filled plate helps reduce drying during prolonged incubation, supporting steady workflows in clinical microbiology. Ideal for those cultivating dermatophytes or maintaining fungal cultures, its nonselective formulation ensures broad usability in routine lab settings.
- Nonselective Fungal Medium – Supports the cultivation of a wide range of fungi, giving you confidence in daily lab work.
- Deep-Filled Plate Design – Minimizes drying during extended incubation, helping maintain sample integrity.
- Standard for Clinical Labs – Recognized as a go-to medium for recovery and maintenance of fungi, ensuring peace of mind for technicians.
- Acidic pH Formulation – Suppresses bacterial growth, so you can focus on accurate fungal isolation.
Reliable Fungal Culture Medium for Clinical Laboratories
This prepared culture media plate offers a trusted solution for cultivating fungi, especially dermatophytes, in clinical and research environments. The deep-fill design helps prevent drying, making it suitable for prolonged incubation periods. Its nonselective nature allows for the recovery and maintenance of a broad spectrum of fungal organisms, while the acidic pH formulation helps suppress unwanted bacterial growth. Laboratories seeking consistent results for routine fungal cultures will appreciate the efficiency and reliability of this medium. Designed for use in clinical microbiology labs, it streamlines daily workflows and supports accurate diagnostics.
Features and Benefits
Optimized for Fungal Growth
- Broad-Spectrum Cultivation – Enables growth of various fungi, including dermatophytes, for comprehensive lab testing.
- Acidic pH of 5.6 – Suppresses bacterial contamination, improving the reliability of fungal cultures.
Deep-Fill Plate Construction
- Minimized Drying – Deep-filled plates help retain moisture during long incubation, preserving sample quality.
- Consistent Media Volume – Ensures uniform results across multiple tests, supporting reproducible outcomes.
Laboratory Efficiency
- Ready-to-Use Format – Saves time and reduces preparation steps for busy lab staff.
- Pack of 100 Plates – Convenient bulk packaging supports high-throughput environments.
Product Specifications
General Information
- Category: Prepared culture media
- Plate Count: 100 plates
- Shelf Life: 147 days
Identification Codes
- SKU: 221278
- GTIN (Each): 00382902212782
- GTIN (Shelfpack): 30382902212783
- GTIN (Bag): 10382902212789
- GTIN (US Standard Pallet): 60382902212784
Explore More: See all Prepared Culture Media | Shop more BD BBL Products
Trusted Performance for Routine Fungal Cultures
Choose this deep-filled agar plate for its proven reliability in clinical and research labs. Its nonselective formulation and moisture-retaining design set it apart from standard media, helping you achieve consistent results. The convenient 100-pack supports high-volume workflows and reduces the need for frequent restocking. Designed for accuracy and ease, this product helps your team maintain confidence in every culture.
- Moisture Retention – Deep-fill design reduces drying, supporting sample stability during long incubations.
- Routine Lab Standard – Widely used in clinical settings for fungal recovery and maintenance.
- Bulk Packaging – 100 plates per pack streamlines inventory and supports busy labs.
- Reliable Results – Consistent media quality helps ensure accurate diagnostics and peace of mind.
Frequently Asked Questions (FAQs)
What is the primary use of this agar plate?
This plate is used for cultivating and maintaining fungi, especially dermatophytes, in clinical laboratories.
How does the deep-fill design benefit laboratory workflows?
The deep-fill design helps minimize drying during prolonged incubation, supporting consistent sample quality.
What is the shelf life of each plate?
Each plate has a shelf life of 147 days, allowing for extended storage and use.
Does the medium suppress bacterial growth?
Yes, the acidic pH formulation helps suppress bacterial growth, supporting accurate fungal isolation.
How many plates are included in each pack?
Each pack contains 100 plates, suitable for high-throughput laboratory environments.
Is this product ready to use upon arrival?
Yes, the plates are prepared and ready to use, saving time for laboratory staff.
What types of fungi can be cultivated with this medium?
This nonselective medium supports the growth of a broad range of fungi, including dermatophytes.